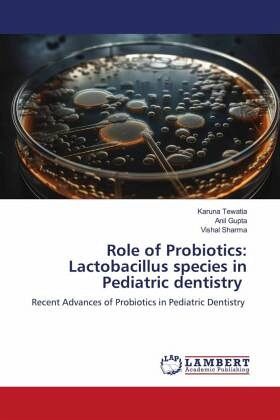
Role of Probiotics: Lactobacillus species in Pediatric dentistry

Role of Probiotics: Lactobacillus species in Pediatric dentistry
Recent Advances of Probiotics in Pediatric Dentistry
Versandkostenfrei!
Versandfertig in 6-10 Tagen
40,99 €
inkl. MwSt.
PAYBACK Punkte
20 °P sammeln!
According to the Food and Agriculture Organization of the United Nations and the World Health Organization (FAO/WHO 2001). Probiotics are "live microorganisms that, when administered in adequate amounts, confer a benefit to the health of the host". Dental caries is a multifactorial disease of bacterial origin that is characterized by acid demineralization of the tooth enamel. Studies have found that probiotics have a beneficial effect in limiting or preventing dental caries, a probiotic must be able to adhere to dental surfaces and integrate into the bacterial communities making up the dental ...
According to the Food and Agriculture Organization of the United Nations and the World Health Organization (FAO/WHO 2001). Probiotics are "live microorganisms that, when administered in adequate amounts, confer a benefit to the health of the host". Dental caries is a multifactorial disease of bacterial origin that is characterized by acid demineralization of the tooth enamel. Studies have found that probiotics have a beneficial effect in limiting or preventing dental caries, a probiotic must be able to adhere to dental surfaces and integrate into the bacterial communities making up the dental biofilm. It must also compete with and antagonize the cariogenic bacteria and thus prevent their proliferation. Different Bacterial species of probiotics have different efficacy in enhancing oral health. Hence, it is important for dentists to understand what are probiotics and how they play a role in oral health and especially in pediatric dentistry.